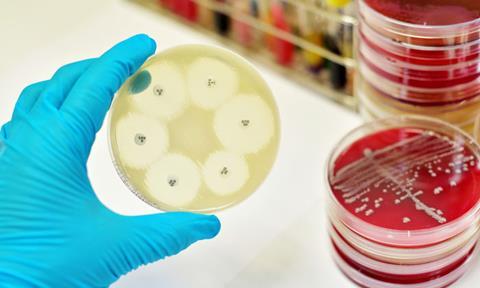
Image

University of Oxford finds rapid metagenomics can produce accurate results 18-42 hours quicker than conventional tests for antimicrobial resistance in bloodstream infections, which could save lives and reduce the misuse of antibiotics.
According to new research presented at European Congress of Clinical Microbiology & Infectious Diseases (ECCMID) in Copenhagen, Denmark (15-18 April), metagenomic sequencing can provide rapid and actionable antimicrobial resistance predictions to treat bloodstream infections much faster than conventional laboratory tests, and has the potential to save lives and better manage the use of antibiotics.
Bloodstream infections can rapidly lead to sepsis, multiple organ failure, and even death. Early and appropriate antibiotic therapy is vital for control of the infection. Antimicrobial resistance is a major challenge when treating bloodstream infections.
“Antibiotic resistant bloodstream infections are a leading killer in hospitals, and rapidly starting the right antibiotic saves lives”, said Dr Kumeren Govender from the John Radcliffe Hospital, University of Oxford. “Our results suggests that metagenomics is a powerful tool for the rapid and accurate diagnosis of pathogenic organisms and antimicrobial resistance, allowing for effective treatment 18 to 42 hours earlier than would be possible using standard culture techniques.”
The current method to identify the pathogen causing the infection is long and laborious, requiring two time-consuming culture and sensitivity tests that take at least 1 to 3 days to complete—first isolating and identifying the pathogen and then performing antimicrobial susceptibility testing.
In contrast, metagenomics sequences all the genetic material including infectious pathogens in a sample all at once, so time spent running tests, waiting for results, and running more tests could be reduced. The new study indicates that rapid metagenomics can provide accurate results within just 6 hours of knowing bacteria are growing in a blood sample.
To find out more, the researchers randomly selected 210 positive and 61 negative blood culture specimens for metagenomic sequencing from the Oxford University Hospital’s microbiology laboratory between December 2020 and October 2022.
DNA was sequenced using the Oxford Nanopore GridION platform. Sequences were used to identify the species of pathogen causing infections, as well as to spot common species that can contaminate blood cultures.
Sequencing was able to identify 99 percent of infecting pathogens including polymicrobial infections and contaminants, as well as giving negative results in 100 percent of culture negative samples. In some instances, sequencing detected probable causes of infection missed by routine cultures, and in other instances identified uncultivable species where a result could not be determined.
Sequencing could also be used to detect antibiotic resistance in the ten most common causes of infections. A total of 741 resistant and 4047 sensitive combinations of antibiotics and pathogens were studied. Results of traditional culture-based testing and sequencing agreed 92 percent of the time. Similar performance could be obtained from raw reads after only two hours of sequencing, overall agreement was 90 percent.
The average time from sample extraction to sequencing was 4 hours with complete AMR prediction 2 hours later, producing actionable antimicrobial resistance results 18-42 hours before to the conventional laboratory.
David Eyre, Professor of Infectious Diseases at the University of Oxford, who co-led the study, commented, “We are working hard to continue to overcome some of the remaining barriers to metagenomic sequencing being used more widely, which include its current high cost, further improving accuracy, and creating improved laboratory expertise in these new technologies and simpler workflows for interpreting results.”


